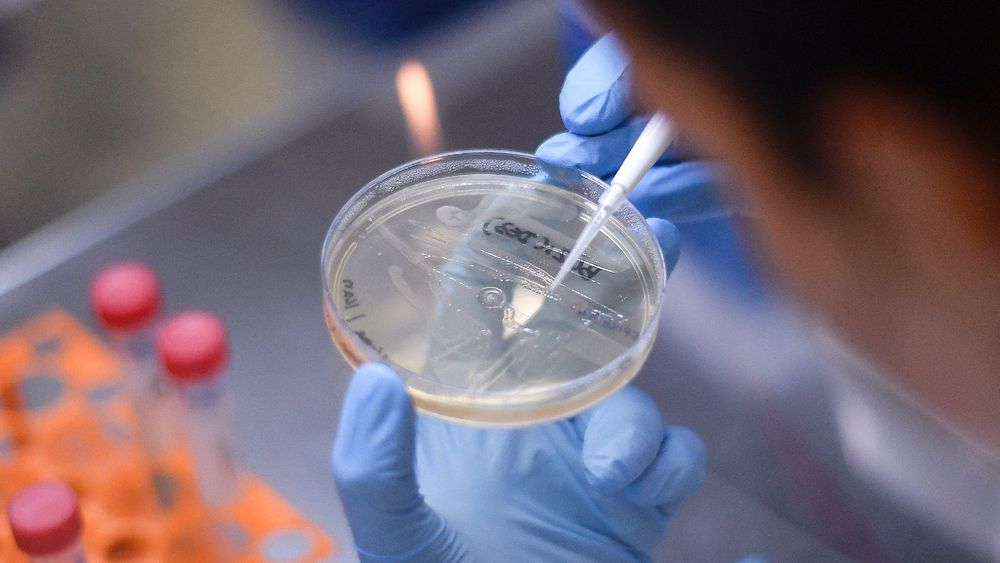

Vous n'êtes pas identifié.
• Annonce ToutSurTout
Déjà 16 ans !

Si vous souhaitez participer vous aussi aux discussions sur le forum, il faut vous inscrire ou vous identifier.
Les inscriptions sont actuellement OUVERTES.
Pages: 1
Réponse : 0 / Vues : 1 403
- Accueil forums
- » Le bar
- » L'Université d'Oxford pense pouvoir fournir un vaccin contre le Covid-19 d'ici septembre
Message 1 Discussion postée le 29-04-2020 à 17:32:14
L'Université d'Oxford pense pouvoir fournir un vaccin contre le Covid-19 d'ici septembre
En cette période de pandémie du Covid-19, les scientifiques du monde entier sont à la recherche du remède contre le virus. L'une des solutions est de pouvoir trouver le vaccin qui permettra de protéger les personnes contre la maladie. Au total, il y a une dizaine de projets de vaccins qui sont passés en phase d'essais cliniques et selon les informations du New York Times, l'un d'entre eux pourrait bien avoir des chances d'être efficace.
Des essais cliniques sur un important panel d'êtres humains.
En effet, le vaccin en question est celui développé par l'institut Jenner de l'Université d'Oxford. Les résultats obtenus après les essais réalisés sur des singes macaques rhésus étaient prometteurs et désormais, les tests vont débuter sur l'homme dans un essai clinique à grande échelle. Cet essai devrait impliquer plus de 6000 personnes d'ici à la fin du mois de mai. Un panel très important quand on constate que dans les autres laboratoires, les essais sur les êtres humains ne se concentrent que sur une centaine de personnes.
Si l'institut Jenner a une longueur d'avance sur les autres laboratoires en quête d'un vaccin contre le Covid-19, c'est parce que l'année dernière, les chercheurs avaient déjà procédé à des essais cliniques sur l'homme pour un autre coronavirus. Les autorités britanniques ont également accéléré le processus en donnant l'autorisation de réaliser des essais sur l'homme pour ce projet de vaccin.
Des résultats prometteurs, mais ne pas crier victoire trop vite.
Le vaccin de l'Université d'Oxford semble prometteur. Le mois dernier, un laboratoire américain du Montana a exposé des primates au Covid-19 et a inoculé ce vaccin à six d'entre eux. Après 28 jours, les primates qui ont reçu la dose unique du vaccin d'Oxford étaient en parfaite santé alors que ceux qui ne l'ont pas reçu avaient tous développé la maladie.
Si les essais sont prometteurs, le Dr. Vincent Munster de l'institut Jenner précise qu'il ne faut pas se précipiter et crier victoire trop vite. Pour l'heure, les scientifiques sont encore à analyser les résultats et le chercheur souligne que même si le macaque rhésus est l'espèce la plus proche de l'Homme, l'immunité chez les singes ne garantit pas nécessairement que le vaccin aura les mêmes effets et la même protection chez les êtres humains.
Vers une distribution en septembre prochain ?
En attendant, si les scientifiques les plus optimistes estimaient qu'un vaccin efficace contre le Covid-19 pourrait faire son apparition au mieux, d'ici la fin de l'année 2020, le New York Times assure que les premiers millions de vaccins d'Oxford pourraient être disponibles à l'horizon de septembre prochain. L'institut Jenner a déjà débuté la phase I des essais cliniques sur 1100 personnes et s'apprête à lancer un essai combiné de phase II et III avec 5000 autres cobayes. Si tous les signaux sont au vert, alors il ne faudra plus que l'autorisation de distribution du vaccin délivrée par l'autorité de santé.


Loic DL un jour, Loic DL toujours ...

Réponse : 0 / Vues : 1 403
Pages: 1
- Accueil forums
- » Le bar
- » L'Université d'Oxford pense pouvoir fournir un vaccin contre le Covid-19 d'ici septembre